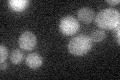
YOR194C
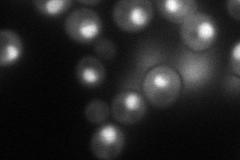
YOR194C
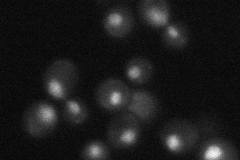
YOR194C
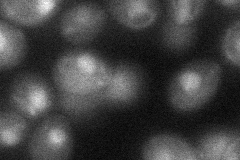
YOR194C

View description
TFIIA large subunit; involved in transcriptional activation, acts as antirepressor or as coactivator; homologous to largest and second largest subunits of human and Drosophila TFIIA
Localization:
Intensity:
Fold change:
Significance:
-
C’ GFP library in SD
below threshold15.78 -
N' NOP1pr-GFP in SD
nucleus91.5513 -
N' TEF2pr-mCherry in SD

nucleus,nucleolus38.3793 -
N' NATIVEpr-GFP in SD
nucleus35.8675 -
N' TEF2pr-VC and Cyto-VN in SD
nucleus32.3675 -
C’ GFP library in SD+DTT

cytosol16.571.04No -
C’ GFP library in SD+H2O2

cytosol16.291.03No -
C’ GFP library in Starvation Media

cytosol19.591.24No -
C’ GFP library on the background of Pup2-DaMP

below threshold -
C’ GFP library on the background of CCT mutant

below threshold16.05781.01713No
